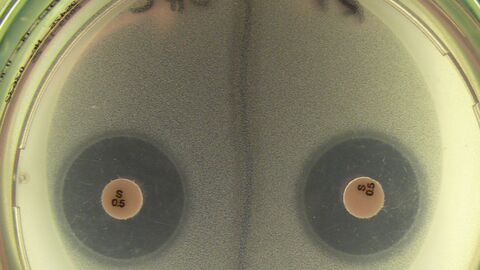

Tritt bei der Schlachtung von Tieren der Verdacht auf, dass das Fleisch mit Krankheitserregern wie Salmonellen oder anderen Keimen belastet sein könnte, wird eine sogenannte bakteriologische Fleischuntersuchung veranlasst. Dazu werden am Schlachtkörper Proben von Muskulatur, Organen sowie Lymphknoten entnommen und auf ihren allgemeinen Keimgehalt sowie auf spezielle Krankheitserreger untersucht. Da bei (möglicherweise) erkrankten Tieren damit gerechnet werden muss, dass sie vor der Schlachtung mit Antibiotika behandelt wurden, wird gleichzeitig ein Hemmstofftest durchgeführt, um zu prüfen, ob Rückstände solcher Medikamente nachweisbar sind.
Unter dem Sammelbegriff Hemmstoffe werden antibakteriell wirksame Stoffe zusammengefasst. Solche Hemmstofftests werden auch bei unauffälligen Schlachtkörpern stichprobenartig durchgeführt, um einen Überblick über die Rückstandsbelastung zu erhalten. Dies geschieht im Rahmen des Nationalen Rückstandskontrollplans, in dem bundesweit Lebensmittel tierischen Ursprungs auf Rückstände von unerwünschten Stoffen untersucht werden. Der Hemmstofftest (sogenannter Dreiplattentest) stellt dabei ein biologisches Screeningverfahren dar, mit dem verdächtige Proben schnell erkannt werden können. Bei positivem Befund werden Art und Menge des Rückstandes mittels chemischer Verfahren bestimmt.
Die regelmäßigen und flächendeckenden Rückstandsuntersuchungen, die bei 0,5 Prozent aller geschlachteten Huftiere bzw. zwei Prozent der geschlachteten Kälber durchgeführt werden, haben wesentlich zum derzeitigen niedrigen Stand von positiven Hemmstoffbefunden (0,1 bis 0,25 Prozent) beigetragen.